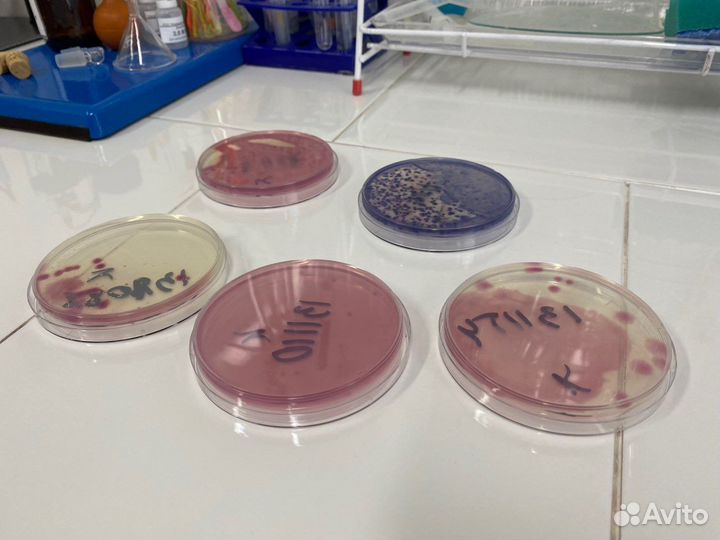
Химический анализ воды в Казани

Химический анализ воды в Казани
1 000 руб.
Источники воды для анализа:
Скважина Колодец
Водопровод Бассейн
Бутилированная воды Родник
Проводим исследование на определение источника воды или протечки.
.
Когда нужен анализ воды?
1. Планируете употреблять воду в сыром виде / изменились вкусовые качества.
2. Пробурили скважину, необходима водоподготовка.
3. Водой пользуются дети до 3х лет.
4. Приобрели бытовую технику, имеющую требования к составу используемой воды
5. По виду своей деятельности должны проводить анализ воды каждые 3 месяца.
.
Преимущества химического анализа воды в Казанской городской лаборатории:
Доступная и профессиональная аналитика (подробная консультация инженера-химика)
Независимый контроль качества воды (не продаем и не навязываем фильтры)
Официальное заключение (для предоставления в государственные органы)
.
Получите подарочный сертификат на скидку 200 руб.
1. Добавьте сейчас это объявление в Избранное ️
2. Напишите нам сообщение "Сертификат" или позвоните.
Подарочный сертификат будет действителен в течение всего 2023 года.
Отвечаем в течение 10 минут. Работаем без выходных.
.
Как отобрать воду для анализа?
Напишите нам на Авито сообщение "инструкция", оперативно отправим Вам в ответ подробную и понятную инструкцию по отбору пробы воды для Вашего источника.
.
Где можно сдать воду на анализ?
Пункт приема воды: г. Казань, Островского д. 57Б. Необходимо заранее выписывать пропуск, при себе иметь удостоверение личности.
Выезд курьера по Казани (бесплатно) и Республике Татарстан (Платно, запись предварительная).
.
Основные профили химического анализа воды:
Базовый - 23 показателя, основные из них, влияющие на безопасное употребление питьевой воды: железо, хлориды, жесткость общая, щелочность общая, мутность с включением полного перечня органолептических показателей.
Комплексный - 35 показателя. Основными загрязнителями воды питьевого назначения являются: железо, сероводород, нитраты, фосфаты, марганец, хлориды, аммоний. По результатам исследования данного вида анализа можно подобрать необходимую систему водоочистки для водопроводной воды или артезианской скважины.
Расширенный - 92 показателя. Это наиболее полный анализ, позволяющий подтвердить санитарно-гигиеническую безопасность источника водоснабжения. Анализ включает определение тяжелых металлов: литий, кадмий, стронций и других химических элементов, оказывающих токсическое воздействие на организм человека, которые невозможно определить органолептическим методом. + Включает все показатели микробиологического анализа.
.
Микробиологический анализ воды:
4 показателя определяющие уровень загрязнения воды общим количеством бактерий и условно-патогенными микроорганизмами, такими как: общие колиформные бактерии, термотолерантные колиформные бактерии, сальмонеллы. Данный вид микробиологического исследования является показателем санитарно-эпидемиологического состояния источника водоснабжение.
.
Когда и как можно получить результаты анализа?
Сроки исследования - от 1 до 5 рабочих дней в зависимости от анализа (есть показатели, которые по ГОСТ измеряются только на 5 сутки после поступления пробы в работу).
Получение заключения - по готовности на электронную почту Заказчика. Оригинал можно забрать самостоятельно в общественной приемной или запросить отправку по Почте России (это бесплатно).
Срочный анализ - если необходимо срочное исследование воды, звоните. Минимальный срок анализа по сокращенному списку показателей 4-5 часов (уточняйте возможность проведения по телефону).
.
Наши лаборатории проводят независимую экспертизу воды с 2014 года.
8 лет лабораторных исследований
> 30000 проверенных источников воды
10 городов присутствия. Внедрена система менеджмента качества
Проверка воды на соответствие нормам СанПиН
Только независимая экспертиза, не продаем фильтры.
.
Наши инженеры-химики могут проконсультировать Вас на темы:
— Как правильно выбрать профиль анализа воды?
— Как правильно отобрать воду для анализа?
— Как часто необходимо делать анализ воды для Вашего источника?
— Как получить консультацию по результатам анализа воды?
— Безопасна ли воды для употребления в сыром виде?
— Как при повторном обращении получить сравнительный анализ по годам?
— Есть ли необходимость в водоподготовке?
— Какой вид и степень фильтрации необходима?
— Как правильно подготовить документы с претензией по качеству воды?
— Какие требования к воде в предприятиях, кафе, автомойках и заправках?
.
Консультация по водоподготовке:
Так как мы производим независимую экспертизу воды, мы не рекламируем Вам конкретного производителя или поставщика оборудования, но, при необходимости, мы проводим максимально подробную консультацию, в которой на основании результатов анализа воды можем порекомендовать Вам вид и необходимую степень фильтрации.
Можем провести сравнительный анализ поступивших Вам предложений по водоподготовке.
Подскажем, необходим ли Вам обратный осмос, удаление железа (обезжелезивание) или УФ обеззараживание (ультрафиолетовые установки), есть ли смысл установить проточный магистральный фильтр для воды или фильтр грубой очистки на воду.
Поможем сориентироваться в системах очистки воды в коттедже, частном доме, нужна ли водоподготовка для бассейна и водоподготовка для котельной, поможем начать ориентироваться в водоподготовке и водоочистке.
.
Партнерская программа для компаний
Предоставляем индивидуальные условия для компаний, занимающихся бурением скважин, строительством колодцев, продажей и установкой систем водоподготовки.
Гарантируем объективность полученных результатов анализа воды.
Предоставляем оптимальную цену и подбор показателей анализа, скидки от объема.
Не передаем результаты анализов воды и данные клиентов третьим лицам.
Выполняем срочные анализы, оперативно проводим анализы большого количества проб.
Можем отправлять курьеров для забора воды к Вам или Вашим Заказчикам.
Сразу выдаем необходимое количество консерванта для последующих анализов воды на содержание сероводорода.
Каждая проба пломбируется, ей присваивается индивидуальный номер, гарантированно доставляется в лабораторию без подмены воды.
Внедрена система менеджмента качества. Все пробы поступают в работу обезличенными. Сотрудники лаборатории не имеют доступа к персональным данным Заказчиков.
.
Звоните или пишите сообщение на Авито.
Оперативно ответим на все вопросы.
Отвечаем в течение 10 минут. Работаем без выходных.
Объвление найдено на сайте avito.ru. Перейдите по ссылке для покупки или просмотра более подробной информации
























